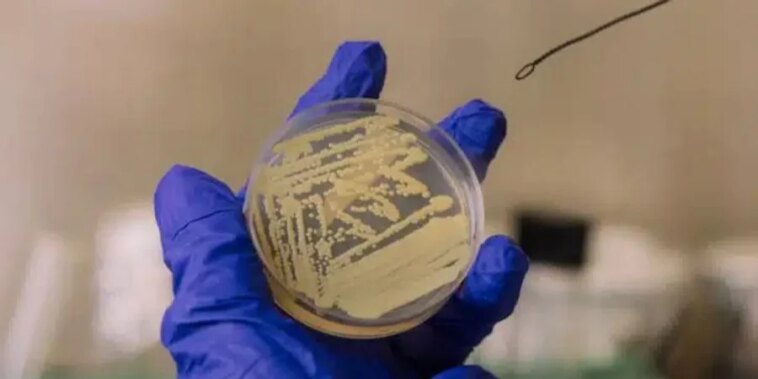

У лабораторіях NASA, які вважаються одними з найчистіших місць на Землі, вчені виявили бактерію, здатну виживати навіть після найсуворіших процедур стерилізації.
NASA могла випадково занести земну бактерію на Марс — нові дані викликають занепокоєння

У лабораторіях NASA, які вважаються одними з найчистіших місць на Землі, вчені виявили бактерію, здатну виживати навіть після найсуворіших процедур стерилізації.

